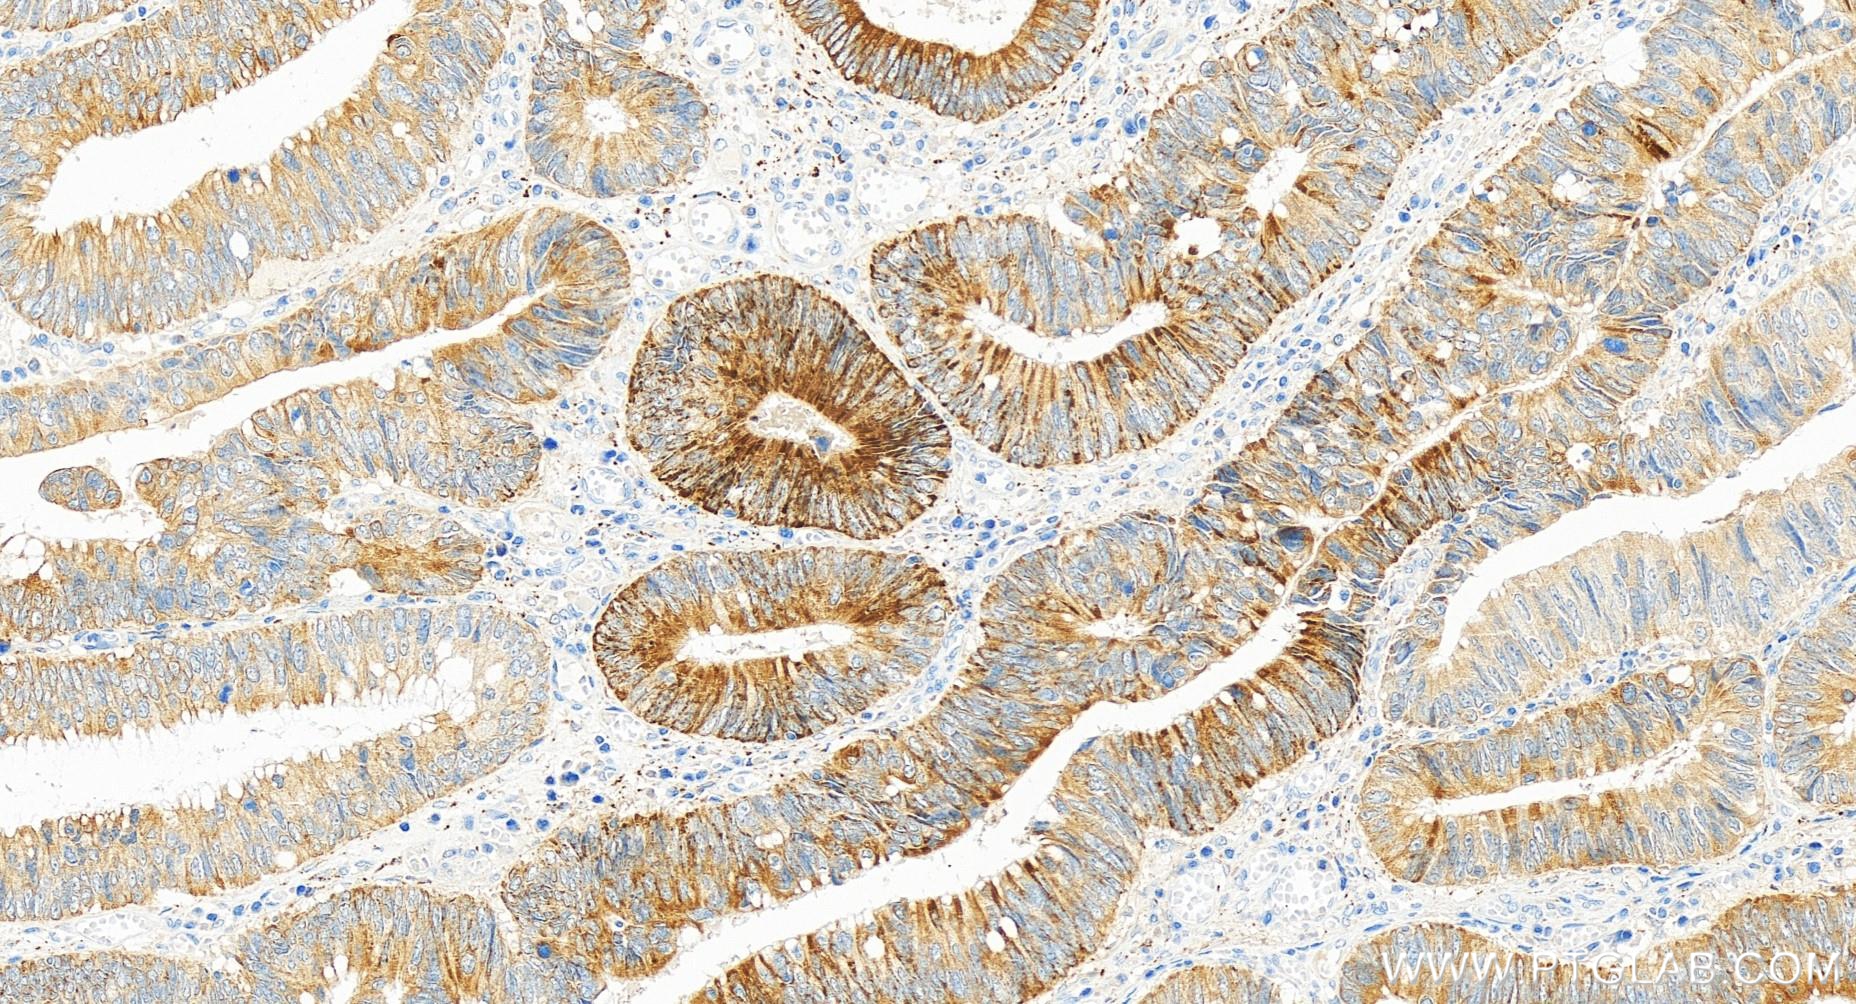

验证数据展示
经过测试的应用
| Positive WB detected in | HCT 116 cells, HEK-293 cells, HL-60 cells |
| Positive IHC detected in | human colon cancer tissue Note: suggested antigen retrieval with TE buffer pH 9.0; (*) Alternatively, antigen retrieval may be performed with citrate buffer pH 6.0 |
推荐稀释比
| 应用 | 推荐稀释比 |
|---|---|
| Western Blot (WB) | WB : 1:500-1:1000 |
| Immunohistochemistry (IHC) | IHC : 1:200-1:800 |
| It is recommended that this reagent should be titrated in each testing system to obtain optimal results. | |
| Sample-dependent, Check data in validation data gallery. | |
产品信息
83710-1-RR targets FHIT in WB, IHC, ELISA applications and shows reactivity with human samples.
| 经测试应用 | WB, IHC, ELISA Application Description |
| 经测试反应性 | human |
| 免疫原 |
CatNo: Ag4181 Product name: Recombinant human FHIT protein Source: e coli.-derived, PGEX-4T Tag: GST Domain: 1-147 aa of BC032336 Sequence: MSFRFGQHLIKPSVVFLKTELSFALVNRKPVVPGHVLVCPLRPVERFHDLRPDEVADLFQTTQRVGTVVEKHFHGTSLTFSMQDGPEAGQTVKHVHVHVLPRKAGDFHRNDSIYEELQKHDKEDFPASWRSEEEMAAEAAALRVYFQ 种属同源性预测 |
| 宿主/亚型 | Rabbit / IgG |
| 抗体类别 | Recombinant |
| 产品类型 | Antibody |
| 全称 | fragile histidine triad gene |
| 别名 | AP3Aase, AP3A hydrolase, Adenylylsulfate-ammonia adenylyltransferase, Adenylylsulfatase, Adenosine 5'-monophosphoramidase FHIT |
| 计算分子量 | 147 aa, 17 kDa |
| 观测分子量 | 15-17 kDa |
| GenBank蛋白编号 | BC032336 |
| 基因名称 | FHIT |
| Gene ID (NCBI) | 2272 |
| RRID | AB_3671313 |
| 偶联类型 | Unconjugated |
| 形式 | Liquid |
| 纯化方式 | Protein A purfication |
| UNIPROT ID | P49789 |
| 储存缓冲液 | PBS with 0.02% sodium azide and 50% glycerol, pH 7.3. |
| 储存条件 | Store at -20°C. Stable for one year after shipment. Aliquoting is unnecessary for -20oC storage. |
背景介绍
The candidate tumor suppressor gene, FHIT(Fragile histidine triad protein), encompasses the common human chromosomal fragile site at 3p14.2, the hereditary renal cancer translocation breakpoint, and cancer cell homozygous deletions. Fhit hydrolyzes dinucleotide 5',5'''-P1,P3-triphosphate in vitro and mutation of a central histidine abolishes hydrolase activity(PMID:9391102). FHIT has a major role in regulating beta-catenin-mediated gene transcription.
实验方案
| Product Specific Protocols | |
|---|---|
| IHC protocol for FHIT antibody 83710-1-RR | Download protocol |
| WB protocol for FHIT antibody 83710-1-RR | Download protocol |
| Standard Protocols | |
|---|---|
| Click here to view our Standard Protocols |